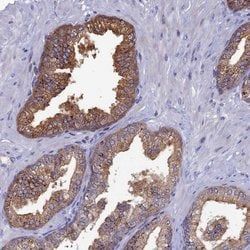
Img

PIPA560885
SPRYD5 Polyclonal Antibody, Invitrogen™
Manufacturer: Thermo Scientific
Select a Size
| Pack Size | SKU | Availability | Price |
|---|---|---|---|
| Each of 1 | PIPA560885-Each-of-1 | In Stock | ₹ 48,905.50 |
PIPA560885 - Each of 1
In Stock
Quantity
1
Base Price: ₹ 48,905.50
GST (18%): ₹ 8,802.99
Total Price: ₹ 57,708.49
Antigen
SPRYD5
Classification
Polyclonal
Conjugate
Unconjugated
Gene
TRIM51
Gene Alias
SPRY domain containing 5; SPRY domain-containing protein 5; SPRYD5; TRIM51; TRIM51A; tripartite motif-containing 51; tripartite motif-containing protein 51
Host Species
Rabbit
Purification Method
Antigen affinity chromatography
Regulatory Status
RUO
Gene ID (Entrez)
84767
Content And Storage
Store at 4°C short term. For long term storage, store at -20°C, avoiding freeze/thaw cycles.
Form
Liquid
Applications
Immunohistochemistry
Concentration
0.2 mg/mL
Formulation
PBS with 40% glycerol and 0.02% sodium azide; pH 7.2
Gene Accession No.
Q9BSJ1
Gene Symbols
TRIM51
Immunogen
Recombinant protein corresponding to Human SPRYD5
Quantity
100 μL
Primary or Secondary
Primary
Target Species
Human
Product Type
Antibody
Isotype
IgG
Description
- Immunogen sequence: DLRSMNVGCD PQDDPDITGK SE Highest antigen sequence identity to the following orthologs: Mouse - 45%, Rat - 42%
- The SPRY domain-containing protein 5 (SPRYD5) is a member of a family of proteins whose sole common characteristic is the presence of a SPRY domain
- SPRY domains are structural domains that were first described in the fungal Dictyostelium discoideum tyrosine kinase spore lysis A
- In most systems SPRY domains provide binding sites for regulatory proteins or intramolecular binding sites that maintain the structural integrity of a protein
- SPRYD5 belongs to the TRIM/RBCC family and contains one B box-type zinc finger, one B30.2/SPRY domain and one RING-type zinc finger
- Little is known of the function of the SPRYD5 protein.
Compare Similar Items
Show Difference
Antigen: SPRYD5
Classification: Polyclonal
Conjugate: Unconjugated
Gene: TRIM51
Gene Alias: SPRY domain containing 5; SPRY domain-containing protein 5; SPRYD5; TRIM51; TRIM51A; tripartite motif-containing 51; tripartite motif-containing protein 51
Host Species: Rabbit
Purification Method: Antigen affinity chromatography
Regulatory Status: RUO
Gene ID (Entrez): 84767
Content And Storage: Store at 4°C short term. For long term storage, store at -20°C, avoiding freeze/thaw cycles.
Form: Liquid
Applications: Immunohistochemistry
Concentration: 0.2 mg/mL
Formulation: PBS with 40% glycerol and 0.02% sodium azide; pH 7.2
Gene Accession No.: Q9BSJ1
Gene Symbols: TRIM51
Immunogen: Recombinant protein corresponding to Human SPRYD5
Quantity: 100 μL
Primary or Secondary: Primary
Target Species: Human
Product Type: Antibody
Isotype: IgG
Antigen:
SPRYD5
Classification:
Polyclonal
Conjugate:
Unconjugated
Gene:
TRIM51
Gene Alias:
SPRY domain containing 5; SPRY domain-containing protein 5; SPRYD5; TRIM51; TRIM51A; tripartite motif-containing 51; tripartite motif-containing protein 51
Host Species:
Rabbit
Purification Method:
Antigen affinity chromatography
Regulatory Status:
RUO
Gene ID (Entrez):
84767
Content And Storage:
Store at 4°C short term. For long term storage, store at -20°C, avoiding freeze/thaw cycles.
Form:
Liquid
Applications:
Immunohistochemistry
Concentration:
0.2 mg/mL
Formulation:
PBS with 40% glycerol and 0.02% sodium azide; pH 7.2
Gene Accession No.:
Q9BSJ1
Gene Symbols:
TRIM51
Immunogen:
Recombinant protein corresponding to Human SPRYD5
Quantity:
100 μL
Primary or Secondary:
Primary
Target Species:
Human
Product Type:
Antibody
Isotype:
IgG
Antigen: ZNF707
Classification: Polyclonal
Conjugate: Unconjugated
Gene: ZNF707
Gene Alias: Zinc finger protein 707; ZNF707
Host Species: Rabbit
Purification Method: Antigen affinity chromatography
Regulatory Status: RUO
Gene ID (Entrez): 286075
Content And Storage: Store at 4°C short term. For long term storage, store at -20°C, avoiding freeze/thaw cycles.
Form: Liquid
Applications: Immunocytochemistry, Immunohistochemistry, Western Blot
Concentration: 0.3 mg/mL
Formulation: PBS with 40% glycerol and 0.02% sodium azide; pH 7.2
Gene Accession No.: Q96C28
Gene Symbols: ZNF707
Immunogen: Recombinant protein corresponding to Human ZNF707
Quantity: 100 μL
Primary or Secondary: Primary
Target Species: Human
Product Type: Antibody
Isotype: IgG
Antigen:
ZNF707
Classification:
Polyclonal
Conjugate:
Unconjugated
Gene:
ZNF707
Gene Alias:
Zinc finger protein 707; ZNF707
Host Species:
Rabbit
Purification Method:
Antigen affinity chromatography
Regulatory Status:
RUO
Gene ID (Entrez):
286075
Content And Storage:
Store at 4°C short term. For long term storage, store at -20°C, avoiding freeze/thaw cycles.
Form:
Liquid
Applications:
Immunocytochemistry, Immunohistochemistry, Western Blot
Concentration:
0.3 mg/mL
Formulation:
PBS with 40% glycerol and 0.02% sodium azide; pH 7.2
Gene Accession No.:
Q96C28
Gene Symbols:
ZNF707
Immunogen:
Recombinant protein corresponding to Human ZNF707
Quantity:
100 μL
Primary or Secondary:
Primary
Target Species:
Human
Product Type:
Antibody
Isotype:
IgG
Antigen: VCY1B
Classification: Polyclonal
Conjugate: Unconjugated
Gene: VCY
Gene Alias: Basic charge, Y-linked 1; basic protein on Y chromosome, 1; BPY1; BPY1B; testis-specific basic protein on Y, 1; testis-specific basic protein Y 1; variable charge, Y chromosome; variable charge, Y-linked; variably charged protein Y; VCY; VCY1; VCY1A; VCY1B
Host Species: Rabbit
Purification Method: Antigen affinity chromatography
Regulatory Status: RUO
Gene ID (Entrez): 9084
Content And Storage: Store at 4°C short term. For long term storage, store at -20°C, avoiding freeze/thaw cycles.
Form: Liquid
Applications: Immunohistochemistry
Concentration: 0.5 mg/mL
Formulation: PBS with 40% glycerol and 0.02% sodium azide; pH 7.2
Gene Accession No.: O14598
Gene Symbols: VCY
Immunogen: Recombinant protein corresponding to Human VCY1B
Quantity: 100 μL
Primary or Secondary: Primary
Target Species: Human
Product Type: Antibody
Isotype: IgG
Antigen:
VCY1B
Classification:
Polyclonal
Conjugate:
Unconjugated
Gene:
VCY
Gene Alias:
Basic charge, Y-linked 1; basic protein on Y chromosome, 1; BPY1; BPY1B; testis-specific basic protein on Y, 1; testis-specific basic protein Y 1; variable charge, Y chromosome; variable charge, Y-linked; variably charged protein Y; VCY; VCY1; VCY1A; VCY1B
Host Species:
Rabbit
Purification Method:
Antigen affinity chromatography
Regulatory Status:
RUO
Gene ID (Entrez):
9084
Content And Storage:
Store at 4°C short term. For long term storage, store at -20°C, avoiding freeze/thaw cycles.
Form:
Liquid
Applications:
Immunohistochemistry
Concentration:
0.5 mg/mL
Formulation:
PBS with 40% glycerol and 0.02% sodium azide; pH 7.2
Gene Accession No.:
O14598
Gene Symbols:
VCY
Immunogen:
Recombinant protein corresponding to Human VCY1B
Quantity:
100 μL
Primary or Secondary:
Primary
Target Species:
Human
Product Type:
Antibody
Isotype:
IgG
Antigen: TOMM20L
Classification: Polyclonal
Conjugate: Unconjugated
Gene: TOMM20L
Gene Alias: TOMM20L; TOMM20-like protein 1; translocase of outer mitochondrial membrane 20 homolog (yeast)-like; translocase of outer mitochondrial membrane 20 homolog type I; translocase of outer mitochondrial membrane 20 like; UNQ9438; UNQ9438/PRO34772
Host Species: Rabbit
Purification Method: Antigen affinity chromatography
Regulatory Status: RUO
Gene ID (Entrez): 387990
Content And Storage: Store at 4°C short term. For long term storage, store at -20°C, avoiding freeze/thaw cycles.
Form: Liquid
Applications: Immunohistochemistry, Western Blot
Concentration: 0.3 mg/mL
Formulation: PBS with 40% glycerol and 0.02% sodium azide; pH 7.2
Gene Accession No.: Q6UXN7
Gene Symbols: TOMM20L
Immunogen: Recombinant protein corresponding to Human TOMM20L
Quantity: 100 μL
Primary or Secondary: Primary
Target Species: Human
Product Type: Antibody
Isotype: IgG
Antigen:
TOMM20L
Classification:
Polyclonal
Conjugate:
Unconjugated
Gene:
TOMM20L
Gene Alias:
TOMM20L; TOMM20-like protein 1; translocase of outer mitochondrial membrane 20 homolog (yeast)-like; translocase of outer mitochondrial membrane 20 homolog type I; translocase of outer mitochondrial membrane 20 like; UNQ9438; UNQ9438/PRO34772
Host Species:
Rabbit
Purification Method:
Antigen affinity chromatography
Regulatory Status:
RUO
Gene ID (Entrez):
387990
Content And Storage:
Store at 4°C short term. For long term storage, store at -20°C, avoiding freeze/thaw cycles.
Form:
Liquid
Applications:
Immunohistochemistry, Western Blot
Concentration:
0.3 mg/mL
Formulation:
PBS with 40% glycerol and 0.02% sodium azide; pH 7.2
Gene Accession No.:
Q6UXN7
Gene Symbols:
TOMM20L
Immunogen:
Recombinant protein corresponding to Human TOMM20L
Quantity:
100 μL
Primary or Secondary:
Primary
Target Species:
Human
Product Type:
Antibody
Isotype:
IgG